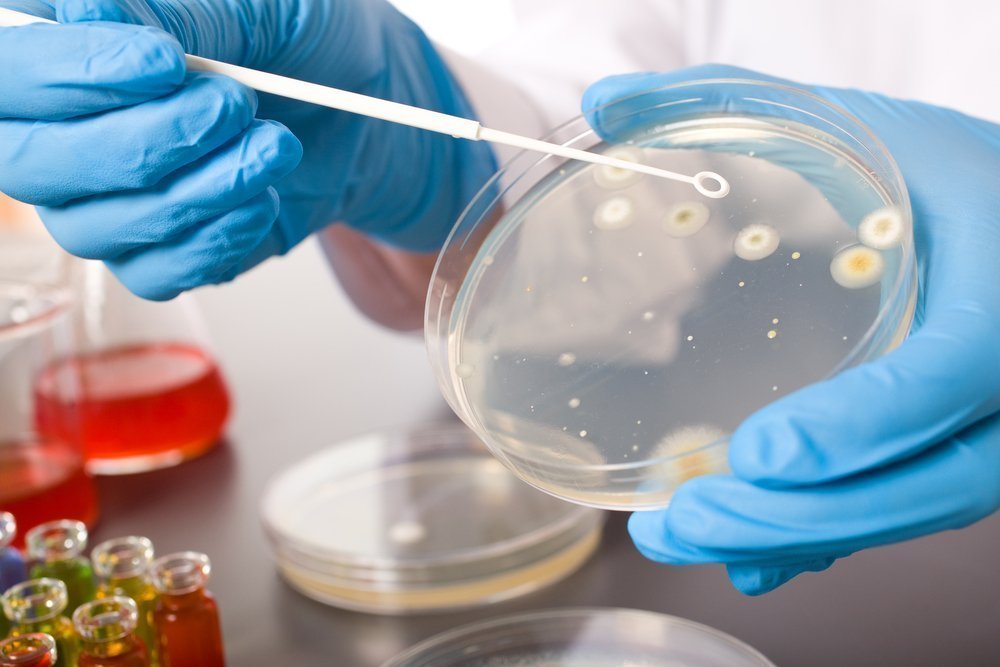
shutterstock_70973383.jpg

С профессиональным праздником собравшихся поздравили: глава Алнашского района Алексей Семенов, депутат Государственной Думы Федерального Собрания Российской Федерации Олег Гарин , заместитель Председателя Государственного Совета Удмуртской Республики Александр Прозоров и начальник Главного управления ветеринарии Удмуртской Республики Роман Габдрахманов.
Много хороших слов прозвучало о ветеринарной службе, но самое главное богатство - это люди, которых судьба свела в этой замечательной службе, и лучшие специалисты ветеринарной службы были награждены за заслуги в труде